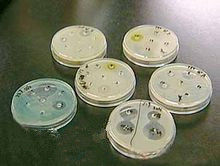
抗生素藥敏試驗

動力學
 葡萄球菌
葡萄球菌本品難以透過正常血腦屏障。蛋白結合率很高,約93%。正常健康人T1/2為0.5~0.7小時;8~15天和20~21天新生兒的T1/2分別為1.6和1.2天。本品約49%(500mg)由肝臟代謝,通過腎小球濾過和腎小管分泌,自腎臟排出體外。肌內注射和口服給藥在尿中排出量分別為40%和23~30%,10~23%尿中排出的藥物為代謝產物。囊腫性纖維化病人的腎小管分泌功能增強,其清除雙氯西林的速率較正常人快3倍,因此其血藥濃度相當低。以甲氧西林等異惡唑組青黴素治療此種病人時,劑量應加大,而且需監測血藥濃度。甲氧西林可經膽汁排泄,本品的膽汁排泄量較其他異惡唑組青黴素者為多。血液透析和腹膜透析皆不能消除甲氧西林。
適應症
主要用於耐青黴素葡萄球菌所致的各種感染,如敗血症、呼吸道感染、腦膜炎、軟組織感染等,也可用於化膿性鏈球菌或肺炎球菌與耐青黴素葡萄球菌所致的混合感染。肺炎球菌、化膿性鏈球菌、其他鏈球菌或對青黴素敏感的葡萄球菌感染則不應採用本品治療。用法用量
 甲氧西林
甲氧西林對輕中度腎功能減退病人,甲氧西林的劑量可不作調整,但對嚴重腎功能減退病人,避免套用過大劑量,以防神經系統等毒性反應的發生。由於本品在肝內代謝量較多,其血清半衰期較短,對嚴重感染採用的劑量仍可較其他異惡唑組青黴素為大。如供肌內注射,每500mg加滅菌注射用水2.8ml;如供靜脈注射,則每1g加滅菌注射用水或氯化鈉注射液10ml。靜脈滴注甲氧西林的溶液濃度一般為20~40mg/ml(快速靜脈滴注)。
不良反應
青黴素引起的各種過敏反應皆可發生於甲氧西林。靜脈注射甲氧西林偶可產生髮熱、噁心、嘔吐和血清轉氨酶升高,肝活檢顯示非特異性肝炎;停藥後症狀消失,可能屬過敏反應。靜脈注射大劑量甲氧西林(每日達18g)可引起抽搐等神經毒性反應,此反應尤易見於腎功能減退病人。偶見有中性粒細胞減少症或粒細胞缺乏症,急性間質性腎炎伴腎功能衰竭也有報告,嬰兒套用大劑量苯唑青黴素後有發生血尿、蛋白尿和尿毒症者。甲氧西林毒性極微,臨床套用發生反應者較少。口服給藥時約15%病人出現胃腸道反應,以輕度中上腹不適、腹脹、食慾減退等為多見。
個別病人也可出現噁心、嘔吐、腹痛、腹瀉等。有時可出現中性細胞減少,但多伴有白細胞減少。有的病人出現肌肉緊張、抽搐、神志不清、頭痛、心悸、血清ALT升高、藥疹、藥熱,偶可發生白色念珠菌繼發感染,一般較輕,不致影響治療,對特異質者,可致出血傾向,個別人氨基轉移酶升高。
肌內注射後,少數病人主訴局部疼痛,且有出現局部硬結者。靜脈給藥如用量大於10.g/日,最好分兩次靜滴,濃度不宜過高,速度宜慢。偶見肝炎及膽汁郁滯之病例。大劑量可有神經系統反應,如神志不清,抽搐,驚厥。
禁忌
本品除禁用於對青黴素類過敏病人外,有過敏性疾病、肝病或新生兒也應慎用。
藥物相互作用
抗生素藥敏試驗
抗生素藥敏試驗阿司匹林、磺胺藥在體內外皆可抑制甲氧西林對血清蛋白的結合,磺胺藥可減少本品在胃腸道的吸收。丙磺舒可延長和增高本品的血藥濃度。二鹽酸奎寧在體外減弱甲氧西林對金葡菌的抗菌活性;本品與西索米星或奈替米星聯合套用可增強本品對金葡菌的抗菌作用。氨苄西林或慶大黴素與本品聯合後可互相增強對腸球菌的作用。本品與其他β-內醯胺類抗生素一樣,與氨基糖苷類混合後,兩者的抗菌活性明顯減弱,因此不能在同一容器內給藥。
藥物治療分析
目的
評價3種檢測耐甲氧西林葡萄球菌(MRS)方法的臨床套用價值。其耐藥性比凝固酶陽性的金黃色葡萄球菌更高,造成臨床治療上的困難。由耐甲氧西林葡萄球菌(methicillinresistantstaphylooocci,MRS)引起的感染已經成為臨床抗感染治療的難題之一。怎樣快速、準確地檢測出MRS及預測其耐藥性變化對臨床治療及合理套用抗生素都有十分重要的意義。分析材料
菌株來源收集了2005年9月至12月本院臨床科室各類標本中分離的葡萄球菌共98株,並經血漿凝固酶試驗和法國生物梅里埃公司生產的VITEK32全自動微生物分析儀系統,配套的GPI和GNI細菌鑑定板鑑定,嚴格按照細菌鑑定程式進行。金黃色葡萄球菌標準菌株ATCC25923。主要試劑GPI細菌鑑定板和GPS藥敏板條為法國生物梅里埃公司產品。頭孢西丁(30μg)紙片為英國OXOID公司商品,藥敏試驗所用培養基MuelleHinton(MH)瓊脂購自杭州微生物試劑廠。mecA基因檢測引物由上海生物工程公司合成。
分析方法
最低抑菌濃度(MIC)測定用GPS-109藥敏鑑定卡在Vitek32全自動微生物分析/藥敏系統測定甲氧西林MIC,遵循美國臨床和實驗室標準化研究所CLSI制定的判斷標準。頭孢西丁紙片擴散試驗按CLSI推薦的Kirby-Bauer法進行,菌液濃度0.5麥氏濁度(1.5×108CFU/ml)。結果判斷標準:金黃色葡萄球菌抑菌圈直徑≤19mm為耐藥,≥20mm為敏感,凝固酶陰性葡萄球菌抑菌圈直徑≤24mm為耐藥,≥25mm為敏感。PCR檢測mecA基因挑取菌落置入內含有100μl生理鹽水的0.5mL離心管內,離心(15000r/min)5min吸棄上清液加裂解液A(0.5%非離子去污劑)50μl和裂解液B(200ug/ml蛋白酶K)5μl置55℃保溫1h後置入95℃保溫5min。離心(10000r/min)30s,上清液即為模板。PCR引物序列P1(5’-GCAATCGCTAAAGAACTAAG-3’),P2(5’-AATGGGACCAACATAACCTA-3’),PCR反應體系50μl,熱循環參數為:94℃預變性5min,94℃1min,48℃1min,72℃1min,循環30次,72℃延伸10min,PCR擴增產物做2%瓊脂糖凝膠電泳,紫外凝膠電泳成像儀下觀察,以224bp處出現螢光條帶為mecA基因陽性。金葡菌ATCC25923作為陰性對照,陽性對照模板DNA
分析結果
98株耐甲氧西林葡萄球菌3種方法檢測結果見表1,以mecA基因檢測呈陽性為“金標準”共檢測出63株耐甲氧西林陽性的葡萄球菌。三種檢測方法經χ2檢驗差異無顯著性(χ2=0.265,P>0.05)。討論
目前臨床上由於MRS的出現致使感染趨勢不斷上升,多重耐藥性增加,現有的抗生素很難控制這些耐藥菌株的感染,給臨床上的治療帶來的困難。正確快速的檢測MRS並找出有效控制其感染的藥物,是目前臨床微生物工作的任務之一。MRS檢測方法有核酸探針技術――PCR檢測法,VITEK儀器測定最低抑菌濃度(MIC)和CLSI推薦鑑定的葡萄球菌的頭孢西丁紙片擴散試驗等方法。為了尋找出適合基層醫院實驗室檢測耐藥性的簡單而又可靠的方法,我們用頭孢西丁紙片擴散法和甲氧西林微量稀釋法與mecA基因的PCR檢測法進行了比較,並評價了它們的可靠性與臨床套用價值。本試驗結果顯示三種方法差異無顯著性,所以此三種方法均為檢測MRS的可靠方法。本文中PCR檢測mecA基因方法被公認為檢測葡萄球菌的“金標準”,其具有快速、簡便、特異性強和敏感性好的特點。並能夠檢測出異質性耐藥的菌株,但由於PCR擴增儀等儀器設備的限制,在基礎常規實驗不易開展。而VITEK儀器測定甲氧西林MIC方法雖然操作簡單,但由於需要VITEK儀器,在基層醫院實驗室也不易開展。頭孢西丁紙片擴散法的敏感性和特異性均較高,實驗條件無特殊要求,且由於頭孢西丁屬頭黴素類抗生素,對金黃色葡萄球菌產生的β-內醯胺酶穩定,並且與金黃色葡萄球菌的PBP4有高親和性,可檢測低水平、異質性耐藥MRS菌株,因此臨床實驗室可常規使用頭孢西丁紙片擴散法進行MRCNS篩檢。
綜合本實驗所用的3種檢測方法,均可作為檢測MRS的可靠方法,但從操作過程,儀器設備,實驗條件,結果敏感性和特異性綜合考慮基層臨床實驗室可常規使用頭孢西丁進行MRS的進行篩選。
副反應案例
 心臟
心臟入院診斷:支氣管肺炎,本患兒及其父母既往均無食物及藥物過敏史,青黴素鈉皮試陰性後,給予甲氧西林0.8靜滴,用藥過程中患兒無哭鬧及任何不適,用藥3天病情好轉,咳嗽喘息減輕,無發熱。第三天靜滴完藥物1小時,患兒出現煩躁、拒乳、哭鬧,查體:面色蒼白,口周及口唇紫紺,呼吸60次/分,急促,心率40次/分,節律不規,四肢末梢發涼,考慮甲氧西林過敏,在給予吸氧的同時,建立靜脈通道,給予腎上腺素0.3mg靜推,氟美松2mg靜推,10%的葡萄糖酸鈣稀釋後靜滴,經過上述處理病情無好轉,5分鐘後又給予腎上腺素0.3mg靜推,面色漸紅潤,心率上升到120次/分,四肢末梢溫暖,患兒哭鬧、煩躁消失。
討論
甲氧西林是半合成耐霉青黴素,主要用於耐酶性葡萄球菌引起的各種感染,也適用於鏈球菌引起的各種感染,用藥前必須做青黴素皮試,皮試陰性後方可套用,一般情況下過敏反應是發生在青黴素皮試過程中,或皮試陰性後用藥不久。本患兒用藥3天后才出現過敏反應,十分罕見,幸虧發現及時、用藥及時,否則後果不堪構想。為防止甲氧西林過敏性休克的發生,我們在臨床工作中,套用甲氧西林應注意以下幾點:1、嚴格掌握適應症和禁忌症。
2、套用甲氧西林前,應仔細詢問有無青黴素過敏史,對於有青黴素過敏史者禁用,患過敏性鼻炎、血清病、蕁麻疹、過敏性哮喘患者,一般不用或慎用。
3、對無過敏史的病人,使用前先做青黴素皮試,青黴素皮試陰性後方可套用,對皮試有輕微反應的,要注意觀察,不可倉促用藥。
4、醫務人員要加強工作責任心,用藥後要隨時觀察患兒的日常情況,特別是24小時內,並囑其父母也應注意觀察,觀察的時間要儘量貫穿於用藥的整個過程中。
5、常備可靠的搶救措施,如腎上腺素注射液、腎上腺皮質激素、異丙嗪、鈣劑、氧氣等。一旦發生過敏,腎上腺素是首選藥物,必要時3~5分鐘可重複套用。

